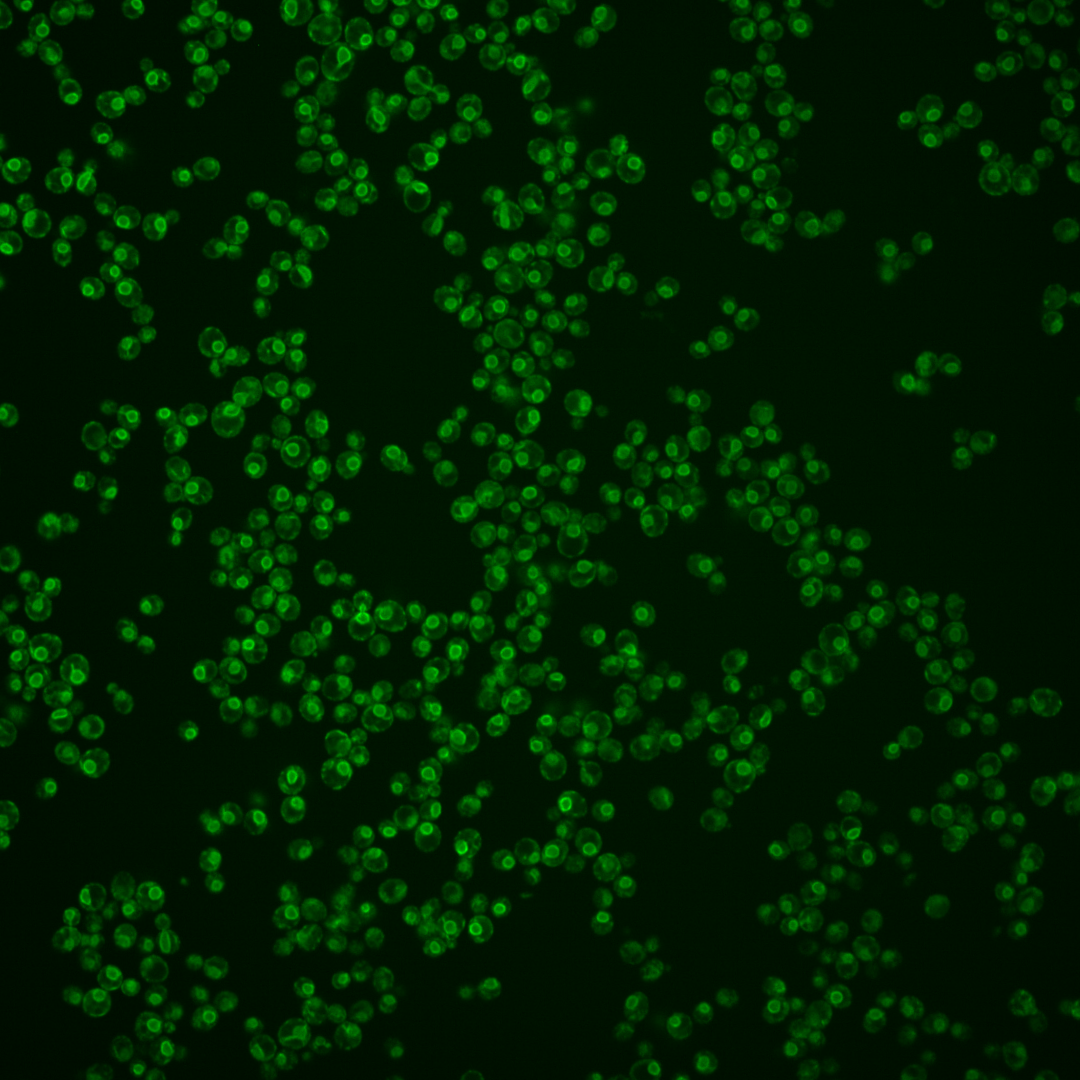
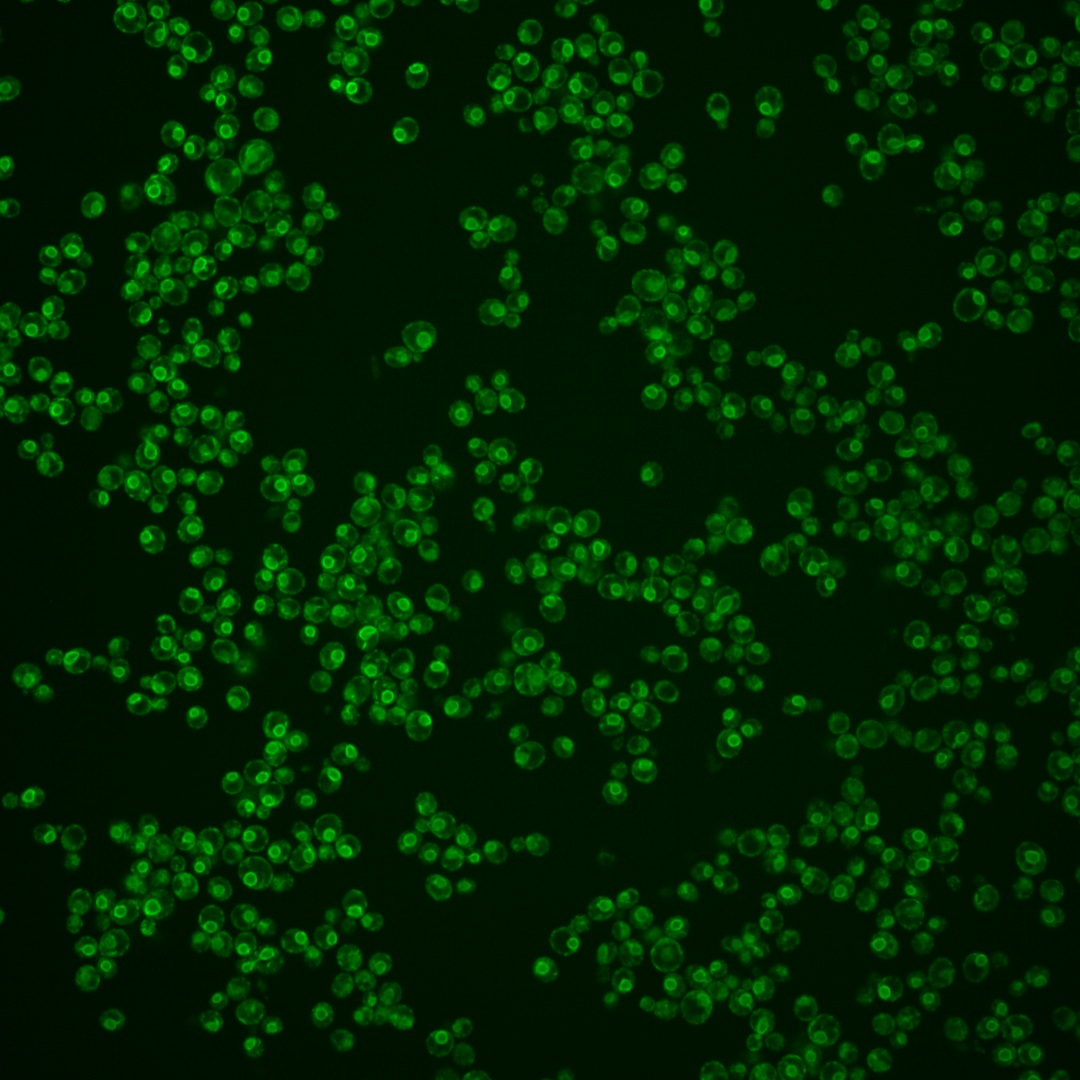
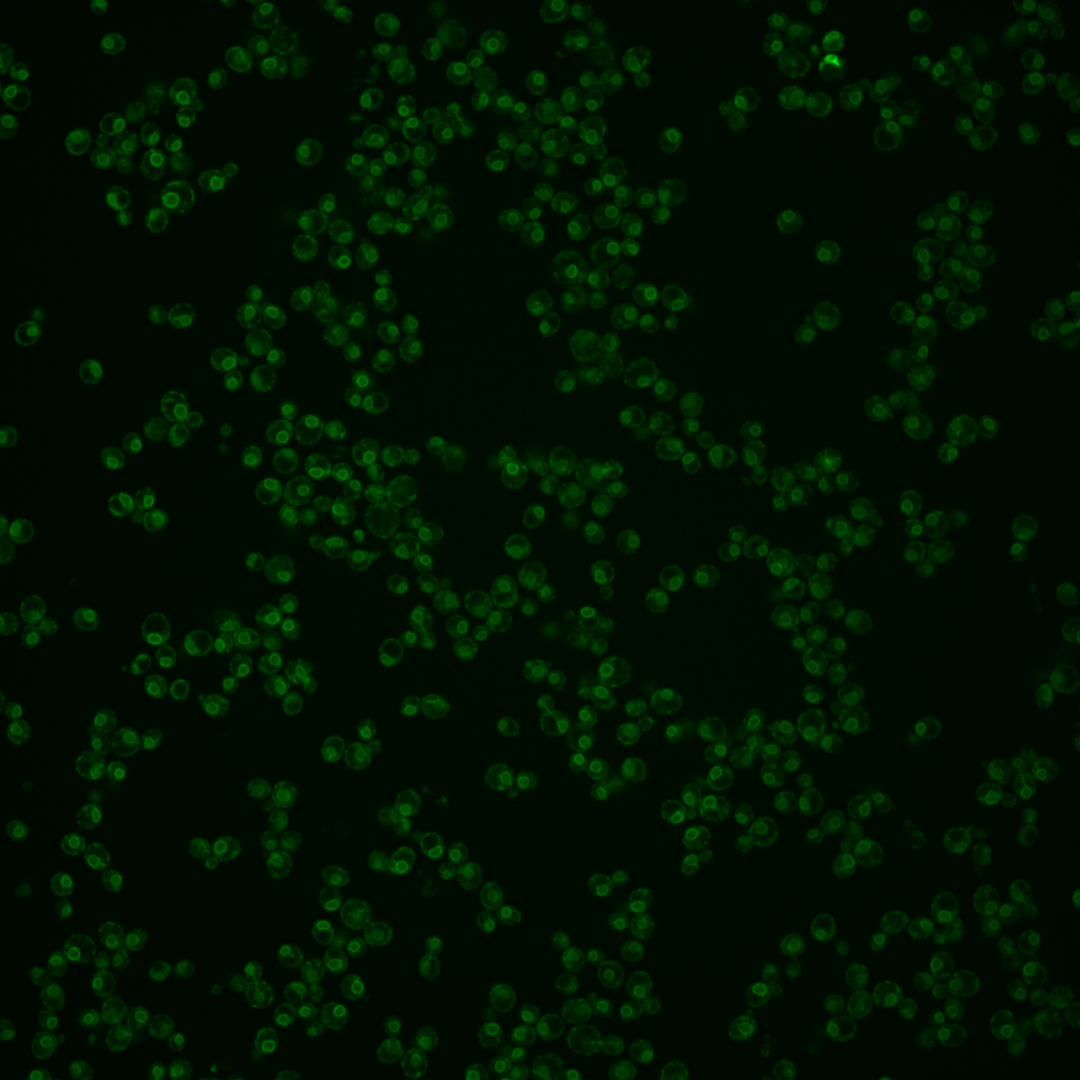

| Standard name | |
|---|---|
| Human Ortholog | |
| Description | ER membrane protein involved in a late step of GPI anchor assembly; involved in the addition of phosphoethanolamine to the multiply mannosylated glycosylphosphatidylinositol (GPI) intermediate; human PIG-Fp is a functional homolog |
Micrographs




















































































Sub-cellular Localization
Yeast GFP Assignment
Protein Abundance
Localization Change
External localization resources
| ensLOC | DeepLoc | |||||||||||||||||||||||
|---|---|---|---|---|---|---|---|---|---|---|---|---|---|---|---|---|---|---|---|---|---|---|---|---|
| Localization | WT1 | WT2 | WT3 | RAP60 | RAP140 | RAP220 | RAP300 | RAP380 | RAP460 | RAP540 | RAP620 | RAP700 | HU80 | HU120 | HU160 | rpd3Δ_1 | rpd3Δ_2 | rpd3Δ_3 | WT1 | WT2 | WT3 | AF100 | AF140 | AF180 |
| Cortical Patches | 3 | 0 | 7 | 13 | 13 | 10 | 3 | – | 8 | 11 | 10 | 27 | 5 | 7 | 5 | 1 | – | – | 1 | 2 | 3 | 1 | 6 | 4 |
| Bud | 0 | 0 | 1 | 1 | 2 | 3 | 1 | – | 1 | 2 | 4 | 6 | 0 | 0 | 0 | 0 | – | – | 0 | 2 | 0 | 0 | 2 | 0 |
| Bud Neck | 0 | 0 | 0 | 0 | 0 | 0 | 0 | – | 0 | 0 | 0 | 0 | 0 | 0 | 0 | 0 | – | – | 0 | 0 | 0 | 0 | 0 | 0 |
| Bud Site | 0 | 0 | 0 | 0 | 0 | 0 | 0 | – | 0 | 0 | 0 | 0 | 0 | 0 | 0 | 0 | – | – | – | – | – | – | – | – |
| Cell Periphery | 1 | 1 | 5 | 4 | 12 | 6 | 10 | – | 5 | 12 | 9 | 21 | 16 | 28 | 30 | 4 | – | – | 0 | 0 | 0 | 0 | 4 | 3 |
| Cytoplasm | 1 | 13 | 15 | 17 | 16 | 26 | 29 | – | 35 | 27 | 57 | 37 | 6 | 13 | 11 | 3 | – | – | 0 | 6 | 1 | 1 | 1 | 5 |
| Endoplasmic Reticulum | 42 | 114 | 142 | 43 | 124 | 74 | 87 | – | 84 | 104 | 87 | 102 | 162 | 166 | 177 | 1 | – | – | 81 | 188 | 226 | 114 | 165 | 186 |
| Endosome | 0 | 0 | 1 | 1 | 0 | 0 | 2 | – | 2 | 0 | 0 | 3 | 0 | 0 | 1 | 0 | – | – | 0 | 0 | 2 | 0 | 1 | 0 |
| Golgi | 6 | 3 | 29 | 11 | 27 | 1 | 10 | – | 2 | 1 | 2 | 2 | 11 | 7 | 6 | 5 | – | – | 3 | 3 | 4 | 0 | 3 | 4 |
| Mitochondria | 6 | 3 | 1 | 15 | 2 | 47 | 4 | – | 32 | 30 | 41 | 72 | 3 | 1 | 0 | 0 | – | – | 2 | 4 | 5 | 3 | 6 | 1 |
| Nucleus | 0 | 0 | 0 | 1 | 1 | 4 | 4 | – | 1 | 4 | 5 | 5 | 0 | 0 | 0 | 1 | – | – | 0 | 0 | 0 | 0 | 0 | 1 |
| Nuclear Periphery | 16 | 11 | 22 | 4 | 1 | 3 | 8 | – | 3 | 3 | 5 | 16 | 21 | 19 | 10 | 0 | – | – | 3 | 8 | 7 | 1 | 1 | 0 |
| Nucleolus | 1 | 0 | 0 | 1 | 0 | 0 | 0 | – | 0 | 1 | 0 | 0 | 0 | 0 | 0 | 0 | – | – | 0 | 0 | 0 | 0 | 0 | 0 |
| Peroxisomes | 0 | 0 | 0 | 0 | 0 | 0 | 0 | – | 0 | 0 | 0 | 0 | 0 | 0 | 0 | 0 | – | – | 0 | 0 | 0 | 0 | 0 | 0 |
| SpindlePole | 0 | 0 | 0 | 0 | 0 | 0 | 0 | – | 0 | 0 | 0 | 0 | 0 | 0 | 0 | 0 | – | – | 0 | 0 | 0 | 0 | 0 | 0 |
| Vac/Vac Membrane | 10 | 66 | 67 | 35 | 42 | 46 | 89 | – | 35 | 34 | 33 | 56 | 4 | 7 | 10 | 2 | – | – | 0 | 13 | 5 | 0 | 3 | 5 |
| Unique Cell Count | 55 | 190 | 222 | 117 | 184 | 169 | 212 | 169 | 191 | 218 | 263 | 177 | 198 | 209 | 16 | 97 | 236 | 261 | 128 | 198 | 217 | |||
| Labelled Cell Count | 86 | 211 | 290 | 146 | 240 | 220 | 247 | 208 | 229 | 253 | 347 | 228 | 248 | 250 | 17 | 97 | 236 | 261 | 128 | 198 | 217 | |||
Yeast GFP Assignment
Protein Abundance
| Screen | WT1 | WT2 | WT3 | RAP60 | RAP140 | RAP220 | RAP300 | RAP380 | RAP460 | RAP540 | RAP620 | RAP700 | HU80 | HU120 | HU160 | rpd3Δ_1 | rpd3Δ_2 | rpd3Δ_3 | AF100 | AF140 | AF180 |
|---|---|---|---|---|---|---|---|---|---|---|---|---|---|---|---|---|---|---|---|---|---|
| Mean Cell GFP Intensity (1e-4) | 15.2 | 15.4 | 15.0 | 13.9 | 14.2 | 9.1 | 12.7 | – | 10.9 | 10.7 | 10.5 | 10.4 | 14.8 | 15.7 | 14.8 | 19.9 | – | – | 13.7 | 15.3 | 15.9 |
| Std Deviation (1e-4) | 3.3 | 3.0 | 2.7 | 3.2 | 2.4 | 2.4 | 2.7 | – | 2.3 | 2.3 | 2.5 | 2.1 | 2.4 | 2.8 | 2.2 | 4.3 | – | – | 2.4 | 2.9 | 2.9 |
| Intensity Change (Log2) | – | – | – | -0.11 | -0.08 | -0.72 | -0.24 | – | -0.46 | -0.48 | -0.51 | -0.53 | -0.01 | 0.06 | -0.02 | 0.41 | – | – | -0.13 | 0.03 | 0.08 |
Localization Change
| Localization | RAP60 | RAP140 | RAP220 | RAP300 | RAP380 | RAP460 | RAP540 | RAP620 | RAP700 | HU80 | HU120 | HU160 | rpd3Δ_1 | rpd3Δ_2 | rpd3Δ_3 |
|---|---|---|---|---|---|---|---|---|---|---|---|---|---|---|---|
| Cortical Patches | 3.0 | 1.8 | 1.3 | 0 | – | 0.8 | 1.3 | 0.8 | 3.1 | -0.2 | 0.2 | -0.5 | 0 | – | – |
| Bud | 0 | 0 | 0 | 0 | – | 0 | 0 | 0 | 0 | 0 | 0 | 0 | 0 | – | – |
| Bud Neck | 0 | 0 | 0 | 0 | – | 0 | 0 | 0 | 0 | 0 | 0 | 0 | 0 | – | – |
| Bud Site | 0 | 0 | 0 | 0 | – | 0 | 0 | 0 | 0 | 0 | 0 | 0 | 0 | – | – |
| Cell Periphery | 0 | 2.1 | 0 | 1.4 | – | 0 | 2.1 | 1.1 | 2.8 | 3.0 | 4.5 | 4.6 | 0 | – | – |
| Cytoplasm | 2.3 | 0.7 | 2.8 | 2.4 | – | 4.1 | 2.5 | 5.5 | 2.6 | -1.5 | -0.1 | -0.7 | 0 | – | – |
| Endoplasmic Reticulum | -4.8 | 0.7 | -4.0 | -4.8 | – | -2.8 | -2.0 | -5.0 | -5.5 | 6.4 | 4.6 | 4.9 | -4.6 | – | – |
| Endosome | 0 | 0 | 0 | 0 | – | 0 | 0 | 0 | 0 | 0 | 0 | 0 | 0 | – | – |
| Golgi | -1.0 | 0.5 | -4.6 | -3.0 | – | -4.3 | -4.9 | -5.0 | -5.5 | -2.3 | -3.5 | -3.9 | 0 | – | – |
| Mitochondria | 5.1 | 0 | 8.2 | 0 | – | 6.5 | 5.9 | 6.6 | 8.3 | 0 | 0 | 0 | 0 | – | – |
| Nucleus | 0 | 0 | 0 | 0 | – | 0 | 0 | 0 | 0 | 0 | 0 | 0 | 0 | – | – |
| Nuclear Periphery | -2.1 | -4.1 | -3.3 | -2.5 | – | -3.3 | -3.5 | -3.3 | -1.6 | 0.6 | -0.1 | -2.0 | 0 | – | – |
| Nucleolus | 0 | 0 | 0 | 0 | – | 0 | 0 | 0 | 0 | 0 | 0 | 0 | 0 | – | – |
| Peroxisomes | 0 | 0 | 0 | 0 | – | 0 | 0 | 0 | 0 | 0 | 0 | 0 | 0 | – | – |
| SpindlePole | 0 | 0 | 0 | 0 | – | 0 | 0 | 0 | 0 | 0 | 0 | 0 | 0 | – | – |
| Vacuole | -0.1 | -1.7 | -0.6 | 2.6 | – | -2.1 | -2.9 | -3.8 | -2.2 | -7.2 | -7.2 | -6.9 | 0 | – | – |
External localization resources
Images






























Protein Concentration and Protein Localization Data
| R1 | R2 | R3 | ||||||||||||||||
|---|---|---|---|---|---|---|---|---|---|---|---|---|---|---|---|---|---|---|
| G1 Pre-START | G1 Post-START | S/G2 | Metaphase | Anaphase | Telophase | G1 Pre-START | G1 Post-START | S/G2 | Metaphase | Anaphase | Telophase | G1 Pre-START | G1 Post-START | S/G2 | Metaphase | Anaphase | Telophase | |
| Concentration | 8.7458 | 9.8718 | 9.5005 | 9.4128 | 7.3841 | 9.8137 | 12.2165 | 13.5195 | 12.8676 | 13.3075 | 12.2201 | 12.4967 | 15.6688 | 16.1895 | 15.8998 | 15.2428 | 18.0904 | 16.4517 |
| Actin | 0.0375 | 0.0006 | 0.0072 | 0.0315 | 0.0035 | 0.008 | 0.0042 | 0.0002 | 0.0145 | 0.0004 | 0.0428 | 0.0102 | 0.0256 | 0.0004 | 0.0066 | 0.0001 | 0.0155 | 0.0026 |
| Bud | 0.0004 | 0.0001 | 0.0003 | 0.0003 | 0.0001 | 0.0001 | 0.0003 | 0 | 0.0002 | 0 | 0.0059 | 0.0001 | 0.0002 | 0 | 0.0002 | 0 | 0.0002 | 0 |
| Bud Neck | 0.0008 | 0.0003 | 0.0007 | 0.0003 | 0.0006 | 0.0003 | 0.0004 | 0.0001 | 0.0005 | 0.0001 | 0.0009 | 0.0006 | 0.0004 | 0 | 0.0033 | 0.0001 | 0.0043 | 0.0001 |
| Bud Periphery | 0.0007 | 0.0002 | 0.0003 | 0.0004 | 0.0002 | 0.0003 | 0.0005 | 0.0001 | 0.0002 | 0.0001 | 0.0112 | 0.0002 | 0.0003 | 0 | 0.0003 | 0.0001 | 0.0003 | 0.0001 |
| Bud Site | 0.0012 | 0.0002 | 0.0007 | 0.001 | 0.0007 | 0.0001 | 0.0019 | 0.0001 | 0.0052 | 0 | 0.0034 | 0.0001 | 0.0003 | 0 | 0.0146 | 0 | 0.0005 | 0 |
| Cell Periphery | 0.0007 | 0.0024 | 0.0003 | 0.0011 | 0.0003 | 0.0001 | 0.0007 | 0.0008 | 0.0006 | 0.0003 | 0.0009 | 0.0002 | 0.0003 | 0.0003 | 0.0009 | 0.0027 | 0.0003 | 0.0001 |
| Cytoplasm | 0.0108 | 0.0076 | 0.0093 | 0.0014 | 0.0064 | 0.0015 | 0.0106 | 0.0168 | 0.0143 | 0.0012 | 0.0027 | 0.0039 | 0.0054 | 0.0051 | 0.0229 | 0.0008 | 0.0481 | 0.0255 |
| Cytoplasmic Foci | 0.0117 | 0.0005 | 0.0083 | 0.0034 | 0.0106 | 0.0048 | 0.0099 | 0.0011 | 0.0132 | 0.001 | 0.0035 | 0.001 | 0.0105 | 0.0001 | 0.0034 | 0 | 0.0044 | 0.0006 |
| Eisosomes | 0.0003 | 0.0001 | 0.0001 | 0.0001 | 0.0002 | 0 | 0.0001 | 0 | 0.0001 | 0 | 0.0002 | 0 | 0.004 | 0 | 0.0001 | 0 | 0.0001 | 0 |
| Endoplasmic Reticulum | 0.6752 | 0.917 | 0.8709 | 0.8619 | 0.7367 | 0.8629 | 0.7219 | 0.9418 | 0.8841 | 0.91 | 0.839 | 0.8781 | 0.7508 | 0.9787 | 0.9031 | 0.9264 | 0.8842 | 0.9219 |
| Endosome | 0.0387 | 0.0045 | 0.0136 | 0.0197 | 0.048 | 0.018 | 0.0507 | 0.0094 | 0.0173 | 0.0188 | 0.0219 | 0.0169 | 0.0164 | 0.0022 | 0.0031 | 0.0023 | 0.006 | 0.0037 |
| Golgi | 0.0179 | 0.0028 | 0.0098 | 0.0109 | 0.023 | 0.0093 | 0.0125 | 0.0015 | 0.0137 | 0.0169 | 0.0106 | 0.0098 | 0.0076 | 0.0007 | 0.0011 | 0.0002 | 0.0035 | 0.0007 |
| Lipid Particles | 0.0159 | 0.0059 | 0.0116 | 0.0309 | 0.0243 | 0.017 | 0.0078 | 0.0085 | 0.0103 | 0.0053 | 0.0318 | 0.004 | 0.0214 | 0.0004 | 0.0014 | 0.0033 | 0.0031 | 0.0024 |
| Mitochondria | 0.0107 | 0.0027 | 0.0149 | 0.006 | 0.0103 | 0.0123 | 0.01 | 0.0016 | 0.0036 | 0.0151 | 0.0084 | 0.0033 | 0.0041 | 0.0005 | 0.0017 | 0.0035 | 0.0003 | 0.0006 |
| None | 0.0048 | 0 | 0.0006 | 0.0001 | 0.0182 | 0.0002 | 0.002 | 0.0001 | 0.0004 | 0 | 0.0003 | 0.0002 | 0.0189 | 0 | 0.0047 | 0.0001 | 0.0003 | 0.0005 |
| Nuclear Periphery | 0.1445 | 0.0428 | 0.037 | 0.0189 | 0.0787 | 0.0576 | 0.1079 | 0.0117 | 0.0134 | 0.0243 | 0.012 | 0.0614 | 0.0972 | 0.0088 | 0.0248 | 0.0461 | 0.0178 | 0.0331 |
| Nucleolus | 0.0006 | 0 | 0.0003 | 0 | 0.0025 | 0.0001 | 0.0006 | 0 | 0.0001 | 0 | 0.0001 | 0 | 0.0011 | 0 | 0.0002 | 0 | 0.0002 | 0.0003 |
| Nucleus | 0.007 | 0.0018 | 0.0016 | 0.0005 | 0.0053 | 0.0017 | 0.0397 | 0.0008 | 0.0008 | 0.0016 | 0.0004 | 0.0038 | 0.0046 | 0.0003 | 0.001 | 0.0011 | 0.0007 | 0.0028 |
| Peroxisomes | 0.0025 | 0 | 0.0041 | 0.0019 | 0.002 | 0.0013 | 0.0044 | 0 | 0.0027 | 0.0002 | 0.0003 | 0.0002 | 0.0107 | 0 | 0.0008 | 0 | 0.0018 | 0.0003 |
| Punctate Nuclear | 0.0055 | 0.0001 | 0.0006 | 0.0002 | 0.0177 | 0.0005 | 0.0018 | 0.0001 | 0.0008 | 0 | 0.0006 | 0.0005 | 0.0129 | 0 | 0.0021 | 0 | 0.0063 | 0.0025 |
| Vacuole | 0.0064 | 0.008 | 0.0039 | 0.0051 | 0.0039 | 0.0021 | 0.0066 | 0.0046 | 0.0033 | 0.0027 | 0.0021 | 0.0031 | 0.003 | 0.0018 | 0.0018 | 0.0078 | 0.001 | 0.0011 |
| Vacuole Periphery | 0.0063 | 0.0022 | 0.0038 | 0.0043 | 0.0067 | 0.0018 | 0.0057 | 0.0006 | 0.0007 | 0.0018 | 0.0011 | 0.0023 | 0.0044 | 0.0005 | 0.0018 | 0.0053 | 0.0008 | 0.0009 |
Sequencing Data
| R1 | R2 | |||||||||
|---|---|---|---|---|---|---|---|---|---|---|
| G1 Post-START | S/G2 | Metaphase | Anaphase | Telophase | G1 Post-START | S/G2 | Metaphase | Anaphase | Telophase | |
| Gene Expression | 19.226 | 26.9012 | 6.6539 | 15.6207 | 32.5139 | 11.6963 | 20.7776 | 25.4972 | 15.4388 | 27.9091 |
| Translational Efficiency | 2.1147 | 1.479 | 2.9466 | 1.356 | 0.9805 | 2.923 | 1.9632 | 1.1005 | 1.7556 | 1.4396 |
Hit Data
| Dataset | Hit |
|---|---|
| Protein Concentration | ✘ |
| Protein Localization | ✘ |
| Gene Expression | ✘ |
| Translational Efficiency | ✘ |
Endocytosis
| Temp | Actin Patch (Sac6-tdTomato) | Cortical Patch (Sla1-GFP) | Late Endosome (Snf7-GFP) | Vacuole (Vph1-GFP) |
|---|---|---|---|---|
| 37℃ | ||||
| RT |
Cell Cycle Omics
CYCLoPs (Gpi11-GFP)
| Gene / Allele | Actin Patch (Sac6-tdTomato) | Cortical Patch (Sla1-GFP) | Late Endosome (Snf7-GFP) | Vacuole (Sac6-tdTomato) |
|---|
| Gene | Images |
|---|
| Gene | Images |
|---|
Images are not yet available
Images are not yet available